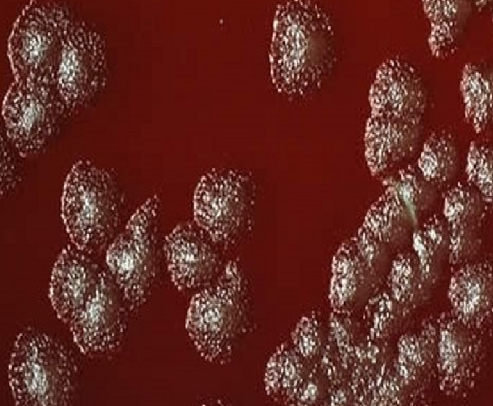

What is Koch’s postulates based on?
Bacillus anthracis
Bacillus anthracis
large, aerobic, gram-positive rods that appear as chains of perfect rectangles that form spores

B. anthracis
catalase positive or negative?
Catalase positive
Does Bacillus sporulate?
yes
Which Bacillus species is not motile?
B. anthracis
Which Bacillus species is not beta-hemolytic on sheep blood agar?
B. anthracis
3 Unique Properties of Bacillus anthracis (versus B. cereus and B. thuringiensis)
- B. anthracis is not beta-hemolytic on sheep agar
- B. anthracis is not motile
- B. anthracis has a glutamyl-polypeptide capsule
Fried Rice Syndrome
common name for disease caused by B. cereus
Rare effects of B. cereus in animals?
gangrene mastitis, abortion, dermatitis/ear infection in dogs
2 Forms of B. cereus Food Poisoning
- Emetic
- Diarrheal
Emetic B. cereus
short incubation (1-6 hours), relatively heat stable
Diarrheal B. cereus
longer incubation than emetic (8-16 hours), can be heat-killed
B. cereus Pathogenesis
found normally in soil, veggies, other foods; too many leads to food poisoning; occurs most often when food is not cooked enough or grows on a buffet
Is fried rice syndrome self limiting?
yes - should resolve on its own within 6-24 hours
What type of agar might B. anthracis be beta hemolytic on?
human or rabbit blood agar (NOT sheep!)
Appearance of B. anthracis
“ground glass”, Medusa-heads
glutamyl-polypeptide capsule
important in virulent strains of B. anthracis; capsules present when bacteria is grown in the presence of CO2
How/when do B. anthracis spores form?
upon exposure to air
Should you ever culture a sample of B. anthracis?
NO - JUST PCR!
so so infectious, it very bad
How to get rid of B. anthracis positive animals?
CREMATION with KEROSENE
do not bury the animal because spores are incredibly stable in the soil (22+ years!)
frank pathogen
always cause disease regardless of the host
Is anthrax zoonotic?
yes
Is B. anthracis a frank pathogen?
yes
Is B. anthracis reportable?
YES


